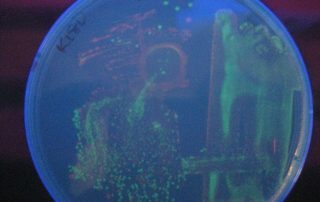

Dr. Todd Eckdahl, Professor
(816) 271-5873 | eckdahl@missouriwestern.edu
Dr. Eckdahl has been at MWSU since 1993. His research interests include Synthetic Biology, BioMath connections, and using molecular cloning techniques to program bacterial computers for the optimization of metabolic pathways.

Development of Course-Based Undergraduate Research Experiences (CUREs) for Genetics
Our group will optimize and expand several existing Course-Based Undergraduate Research Experiences (CUREs) for use in Genetics teaching laboratory sections that are currently used in BIO205 at Missouri Western.
The existing CUREs involve cloning original genetic regulatory elements in E. coli, measuring evolution in Drosophila populations with PCR of microsatellites, and construction of phylogenetic trees with molecular data. We will also develop new CUREs for Genetics that enable students to explore yeast genetics, patterns of inheritance in Drosophila, DNA supercoiling, and personal genomics.
Requirements: Successful completion of BIO205 Genetics.
Invention of New Synthetic Biology Methods for Metabolic Engineering
Our research group will investigate several approaches to the use of synthetic biology for the metabolic engineering of bacteria. We will use both in vivo and in vitro methods to optimize methods by which scientists can optimize the output of metabolic pathways for the production of desired products with applications in energy, medicine, and the environment.
Requirements: Successful completion of BIO205 Genetics.

About Dr. Todd T. Eckdahl
Ph.D., Molecular Genetics, Purdue University
B.S., Chemistry, University of Minnesota at Duluth
Contact Dr. Eckdahl
Agenstein 237J
4525 Downs Drive
Saint Joseph, MO 64507
USA